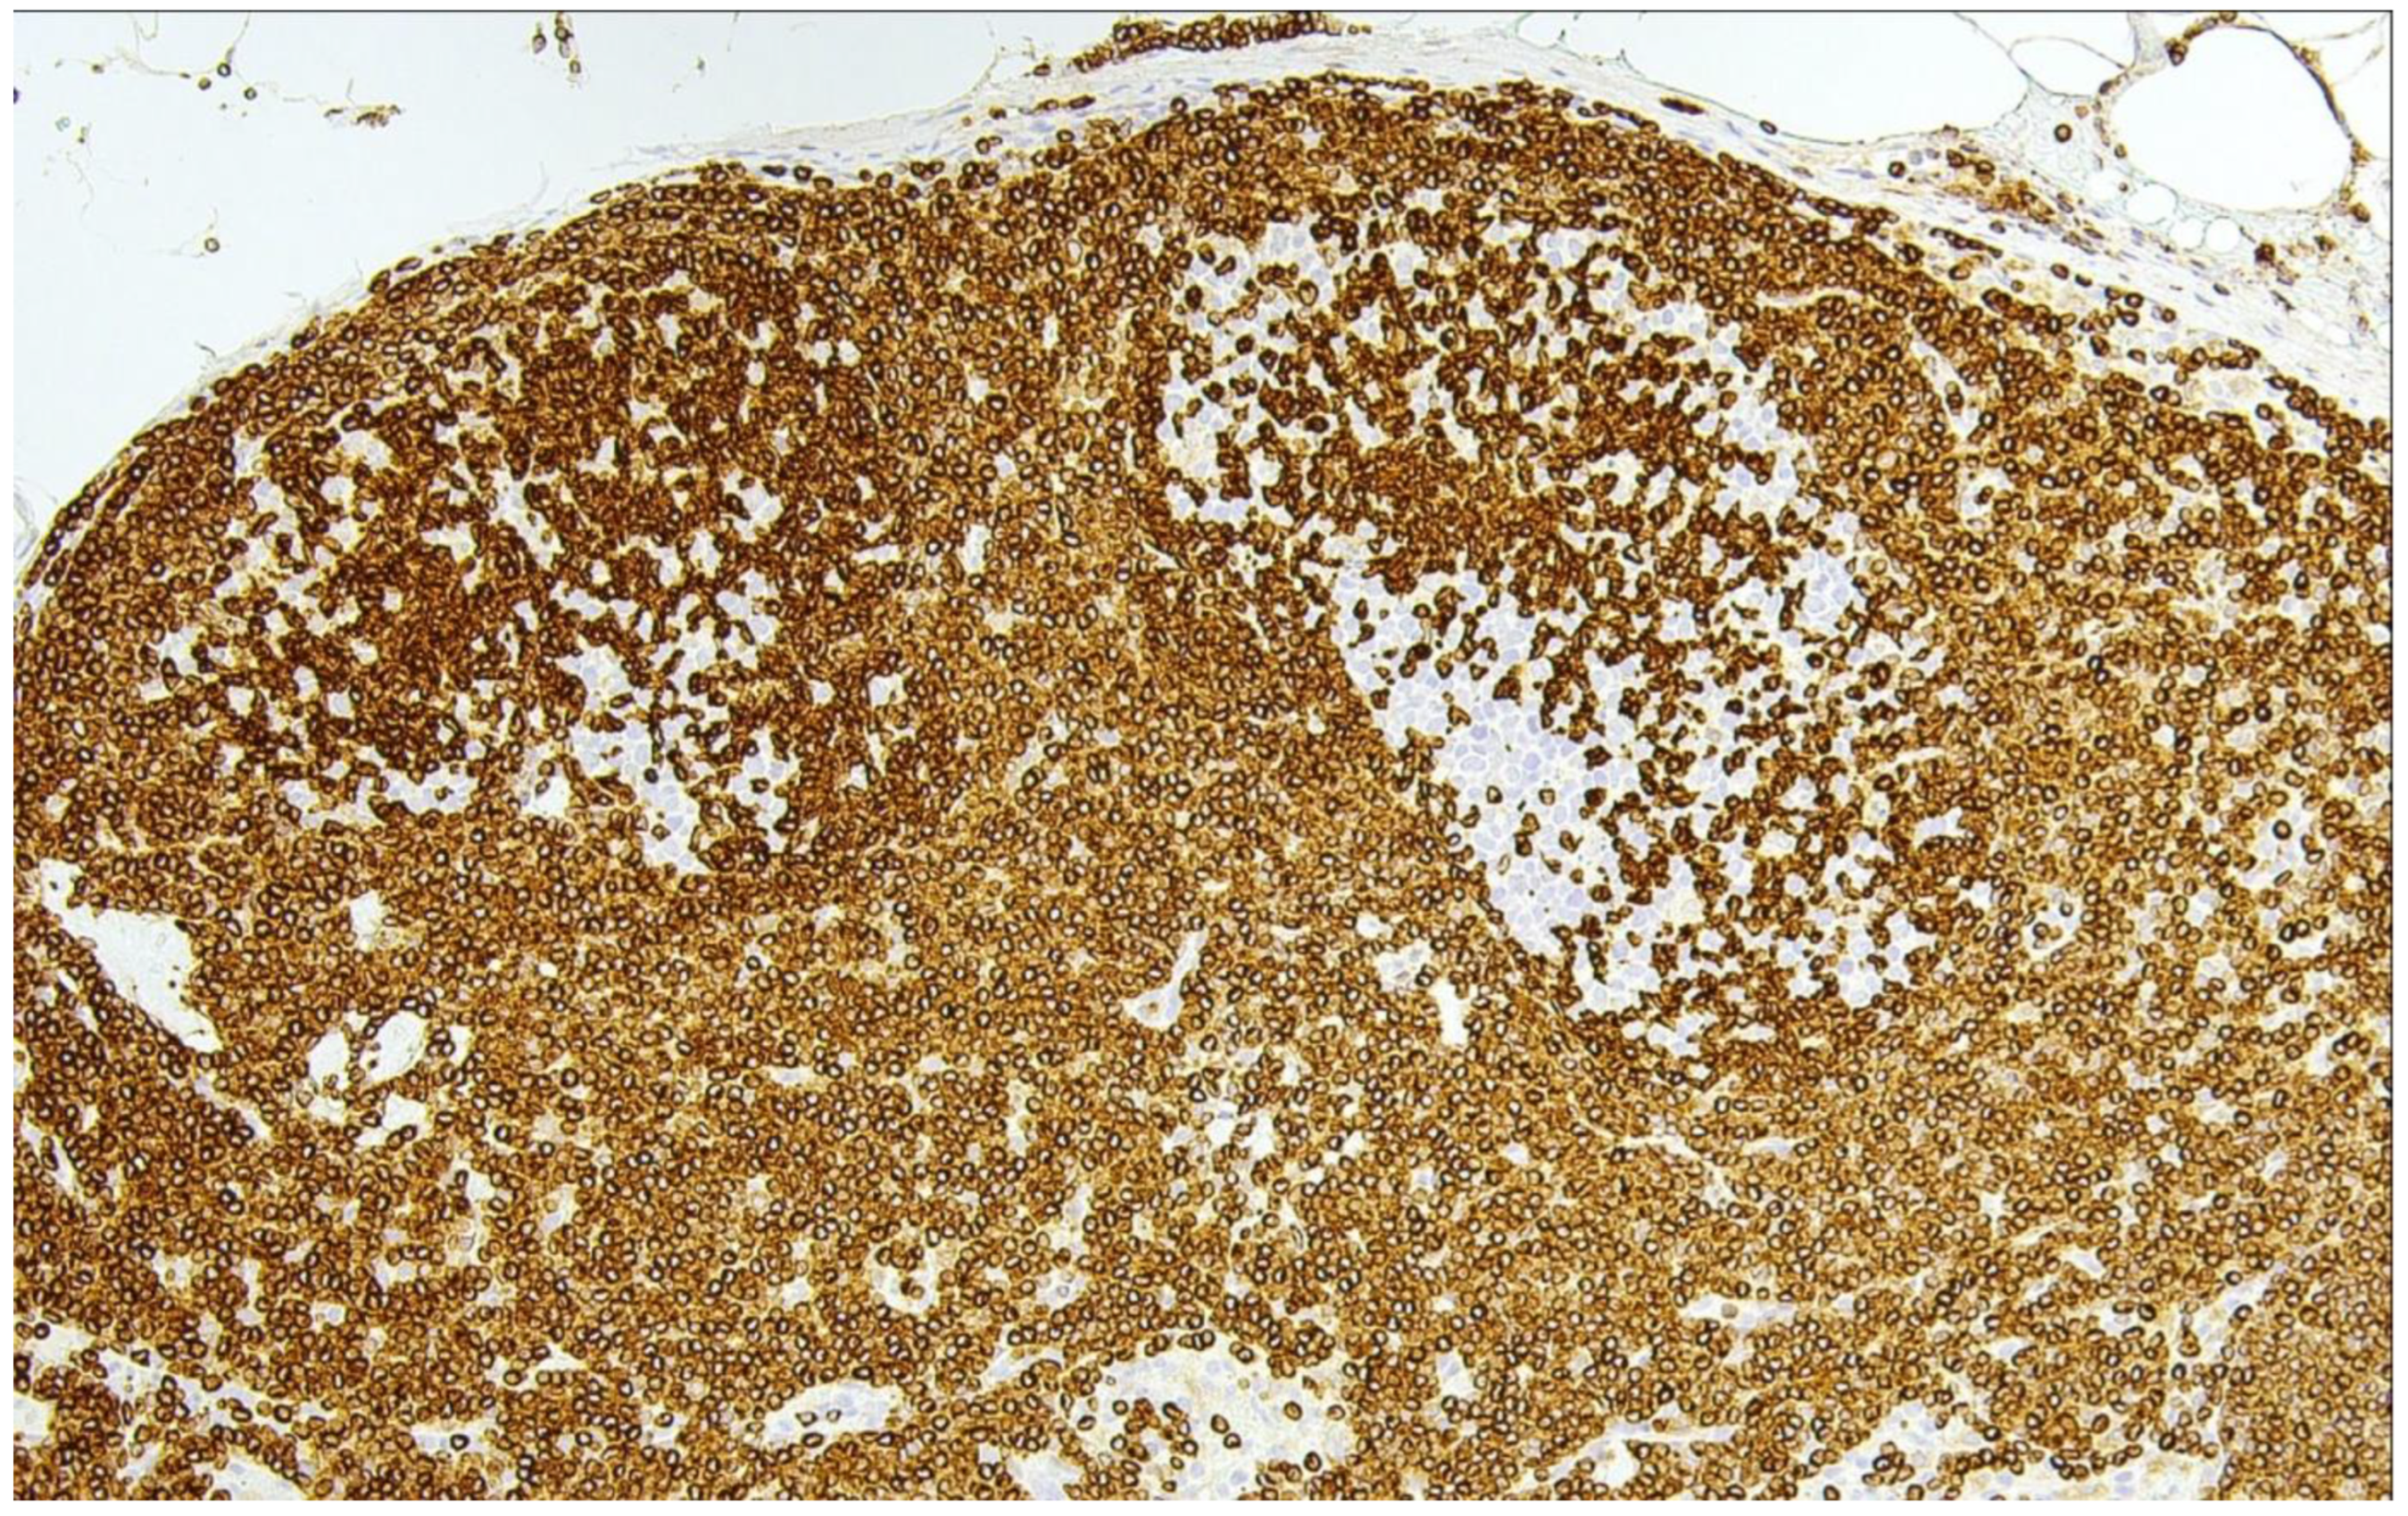
Cancers 15 00785 g001
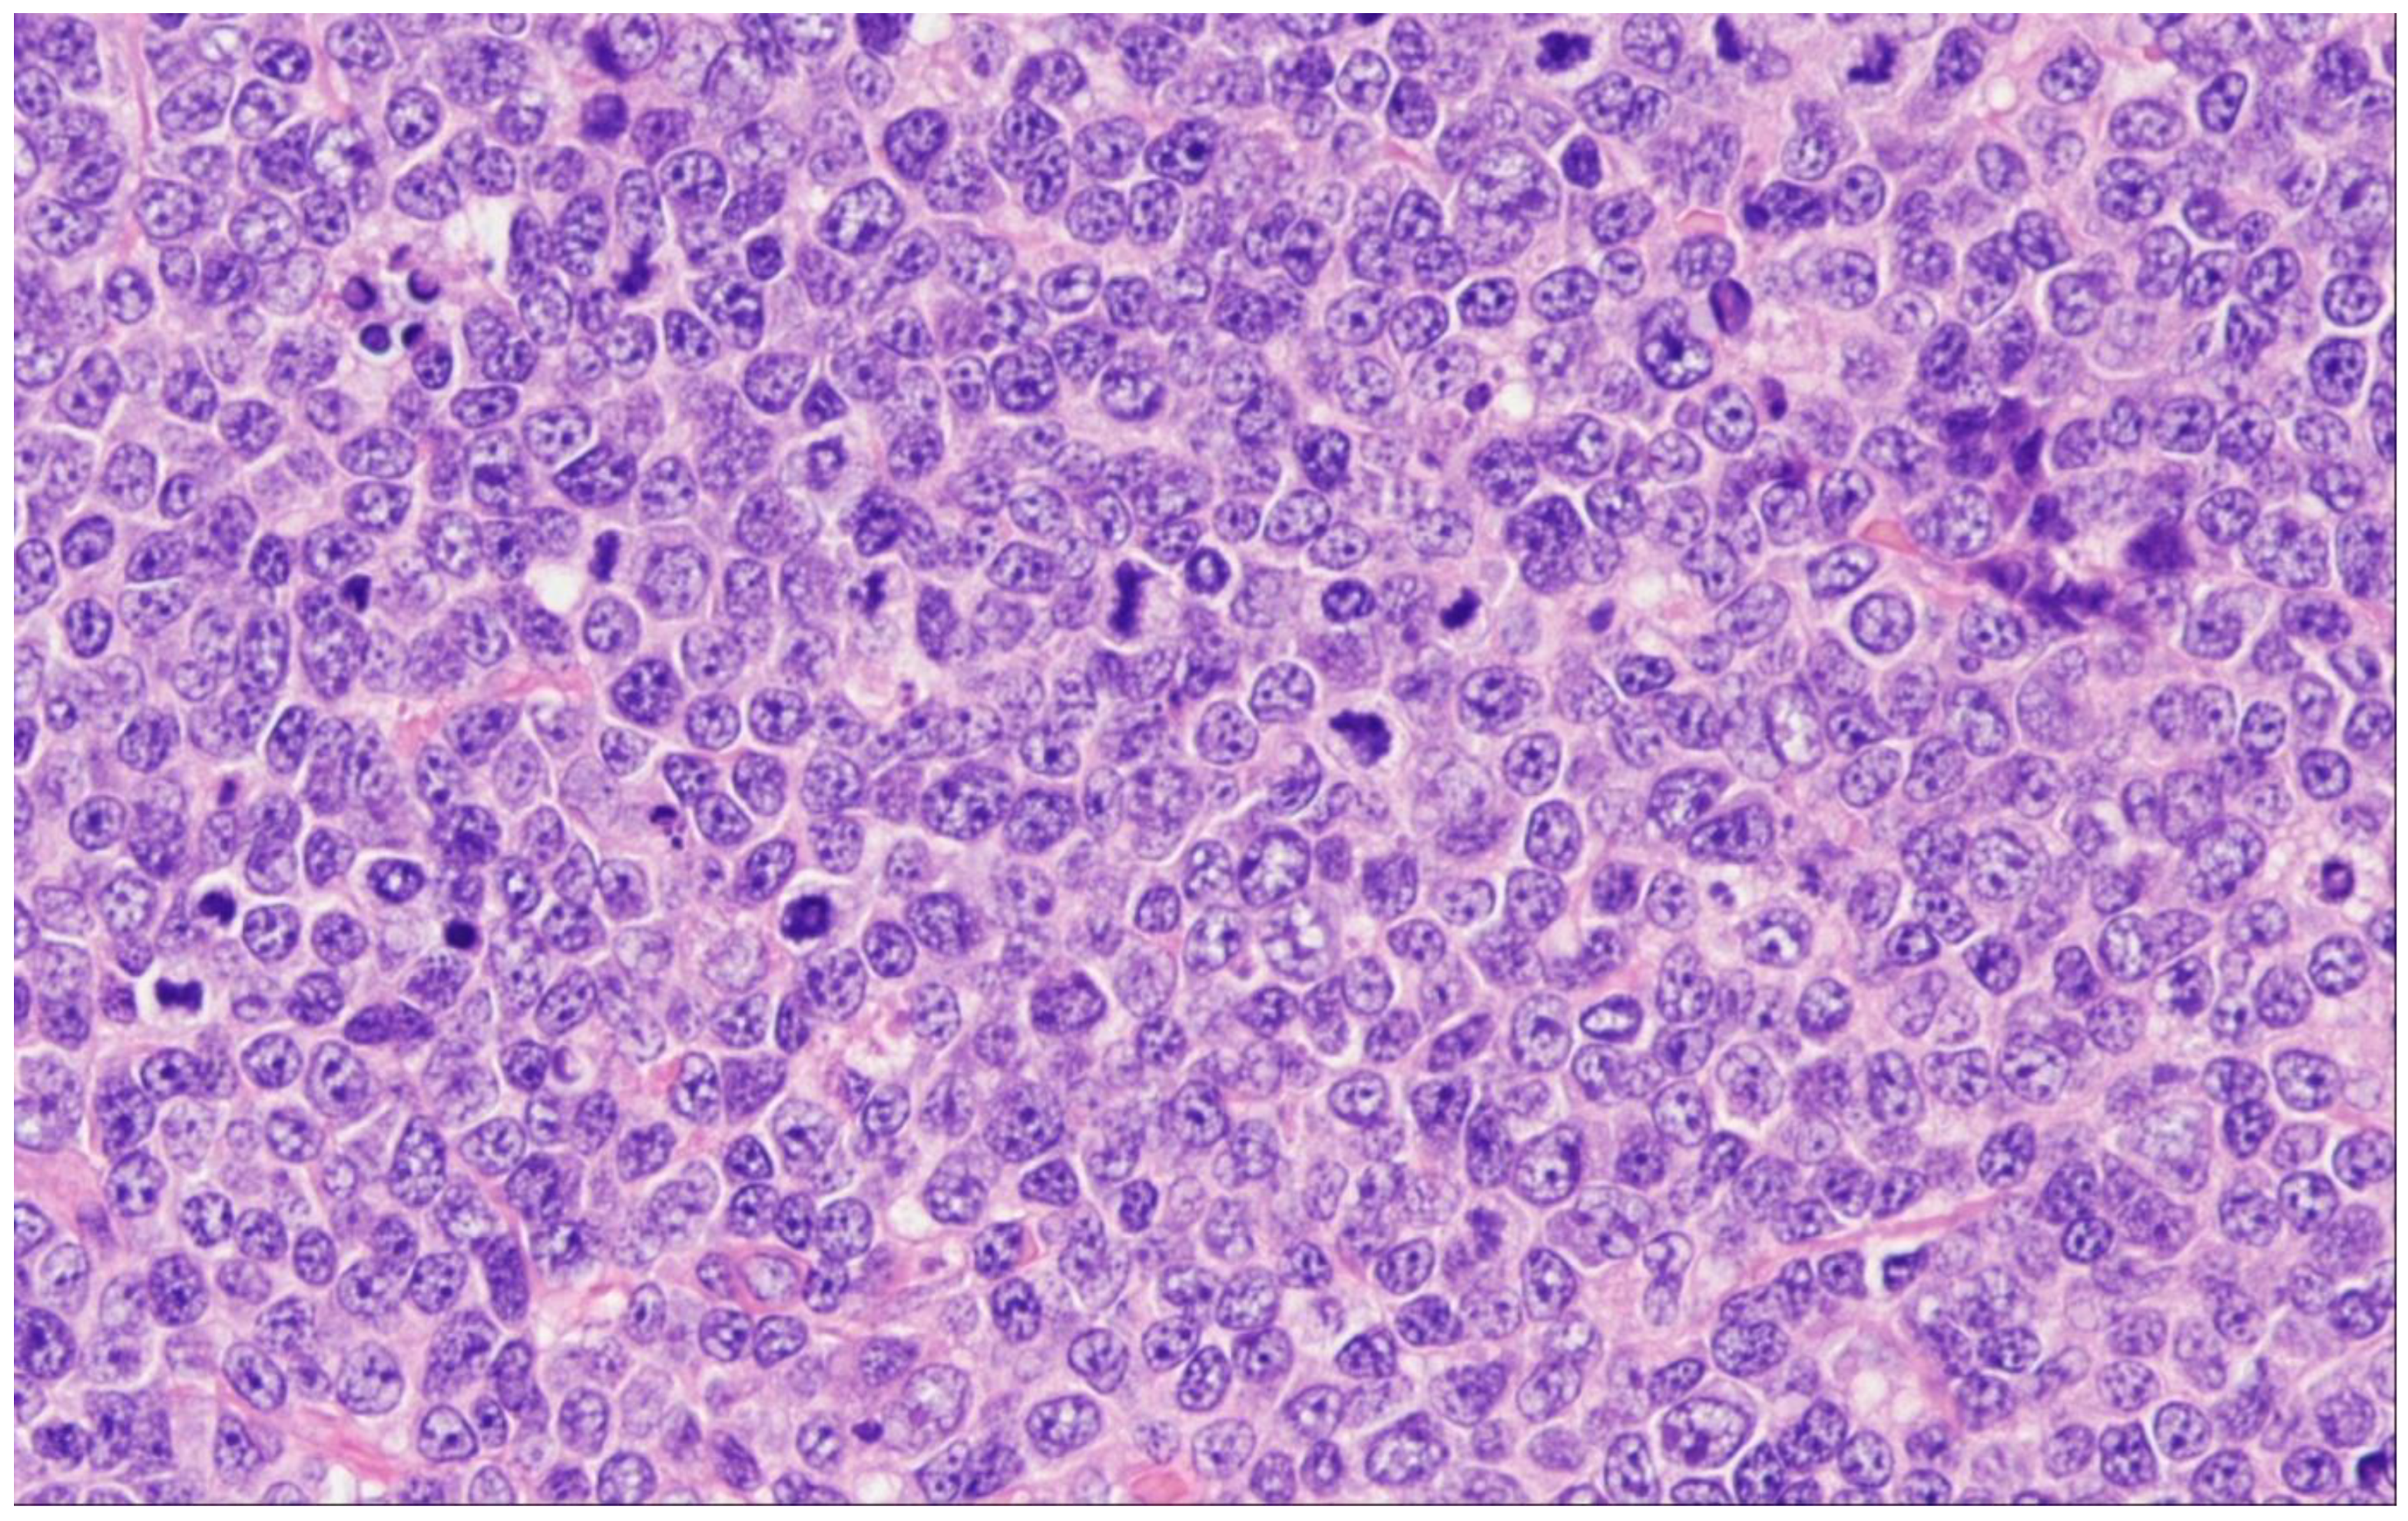
Cancers 15 00785 g004

Follicular Lymphoma in the 5th Edition of the WHO-Classification of Haematolymphoid Neoplasms—Updated Classification and New Biological Data
Abstract
Simple Summary
Abstract
1. Introduction
2. WHO-HAEM5 and the Chapter on FL
3. In-Situ Follicular B-Cell Neoplasm
4. Classic FL
5. Follicular Lymphoma with Unusual Cytologic Features
6. Predominantly Diffuse FL
7. Follicular Large B-Cell Lymphoma
8. Pediatric-Type Follicular Lymphoma
9. Duodenal-Type Follicular Lymphoma
10. Primary Cutaneous Follicle Center Lymphoma
11. Perspective
12. Conclusions and Future Directions
Funding
Conflicts of Interest
References
- Jaffe, E.S.; Harris, N.L.; Stein, H.; Vardiman, J.W. World Health Organization Classification of Tumours of Haematopoietic and Lymphoid Tissues, 3rd ed.; International Agency for Research on Cancer Press: Lyon, France, 2001. [Google Scholar]
- Swerdlow, S.H.; Campo, E.; Harris, N.L.; Jaffe, E.S.; Pileri, S.A.; Stein, H.; Thiele, J.; Vardiman, J.W. World Health Organization Classification of Tumours of Haematopoietic and Lymphoid Tissues, 4th ed.; International Agency for Research on Cancer Press: Lyon, France, 2008. [Google Scholar]
- Swerdlow, S.H.; Campo, E.; Harris, N.L.; Jaffe, E.S.; Pileri, S.A.; Stein, H.; Thiele, J.; Arber, D.A.; Hasserjian, R.P.; Le Beau, M.M.; et al. World Health Organization Classification of Tumours of Haematopoietic and Lymphoid Tissues, Revised 4th ed.; International Agency for Research on Cancer Press: Lyon, France, 2017. [Google Scholar]
- Teras, L.R.; DeSantis, C.E.; Cerhan, J.R.; Morton, L.M.; Jemal, A.; Flowers, C.R. 2016 US lymphoid malignancy statistics by World Health Organization subtypes. CA Cancer J. Clin. 2016, 66, 443–459. [Google Scholar] [CrossRef] [PubMed]
- Campo, E.; Jaffe, E.S.; Cook, J.R.; Quintanilla-Martinez, L.; Swerdlow, S.H.; Anderson, K.C.; Brousset, P.; Cerroni, L.; de Leval, L.; Dirnhofer, S.; et al. The International Consensus Classification of Mature Lymphoid Neoplasms: A report from the Clinical Advisory Committee. Blood 2022, 140, 1229–1253. [Google Scholar] [CrossRef] [PubMed]
- Dreyling, M.; Ghielmini, M.; Rule, S.; Salles, G.; Ladetto, M.; Tonino, S.H.; Herfarth, K.; Seymour, J.F.; Jerkeman, M. Newly diagnosed and relapsed follicular lymphoma: ESMO Clinical Practice Guidelines for diagnosis, treatment and follow-up. Ann. Oncol. 2021, 32, 298–308. [Google Scholar] [CrossRef] [PubMed]
- Batlevi, C.L.; Sha, F.; Alperovich, A.; Ni, A.; Smith, K.; Ying, Z.; Soumerai, J.D.; Caron, P.C.; Falchi, L.; Hamilton, A.; et al. Follicular lymphoma in the modern era: Survival, treatment outcomes, and identification of high-risk subgroups. Blood Cancer J. 2020, 10, 74. [Google Scholar] [CrossRef]
- Nooka, A.K.; Nabhan, C.; Zhou, X.; Taylor, M.D.; Byrtek, M.; Miller, T.P.; Friedberg, J.W.; Zelenetz, A.D.; Link, B.K.; Cerhan, J.R.; et al. Examination of the follicular lymphoma international prognostic index (FLIPI) in the National LymphoCare study (NLCS): A prospective US patient cohort treated predominantly in community practices. Ann. Oncol. 2013, 24, 441–448. [Google Scholar] [CrossRef]
- Pastore, A.; Jurinovic, V.; Kridel, R.; Hoster, E.; Staiger, A.M.; Szczepanowski, M.; Pott, C.; Kopp, N.; Murakami, M.; Horn, H.; et al. Integration of gene mutations in risk prognostication for patients receiving first-line immunochemotherapy for follicular lymphoma: A retrospective analysis of a prospective clinical trial and validation in a population-based registry. Lancet Oncol. 2015, 16, 1111–1122. [Google Scholar] [CrossRef]
- Federico, M.; Caballero Barrigón, M.D.; Marcheselli, L.; Tarantino, V.; Manni, M.; Sarkozy, C.; Alonso-Álvarez, S.; Wondergem, M.; Cartron, G.; Lopez-Guillermo, A.; et al. Rituximab and the risk of transformation of follicular lymphoma: A retrospective pooled analysis. Lancet Haematol. 2018, 5, e359–e367. [Google Scholar] [CrossRef]
- Rimsza, L.M.; Li, H.; Braziel, R.M.; Spier, C.M.; Persky, D.O.; Dunlap, J.; LeBlanc, M.; Bartlett, N.; Leonard, J.P.; Smith, S.M.; et al. Impact of histological grading on survival in the SWOG S0016 follicular lymphoma cohort. Haematologica 2018, 103, e151–e153. [Google Scholar] [CrossRef]
- Kroft, S.H. Stratification of Follicular Lymphoma: Time for a Paradigm Shift? Am. J. Clin. Pathol. 2019, 151, 539–541. [Google Scholar] [CrossRef]
- Hiddemann, W.; Barbui, A.M.; Canales, M.A.; Cannell, P.K.; Collins, G.P.; Dürig, J.; Forstpointner, R.; Herold, M.; Hertzberg, M.; Klanova, M.; et al. Immunochemotherapy With Obinutuzumab or Rituximab for Previously Untreated Follicular Lymphoma in the GALLIUM Study: Influence of Chemotherapy on Efficacy and Safety. J. Clin. Oncol. 2018, 36, 2395–2404. [Google Scholar] [CrossRef]
- Morschhauser, F.; Fowler, N.H.; Feugier, P.; Bouabdallah, R.; Tilly, H.; Palomba, M.L.; Fruchart, C.; Libby, E.N.; Casasnovas, R.-O.; Flinn, I.W.; et al. Rituximab plus Lenalidomide in Advanced Untreated Follicular Lymphoma. N. Engl. J. Med. 2018, 379, 934–947. [Google Scholar] [CrossRef] [PubMed]
- Henopp, T.; Quintanilla-Martínez, L.; Fend, F.; Adam, P. Prevalence of follicular lymphoma in situ in consecutively analysed reactive lymph nodes. Histopathology 2011, 59, 139–142. [Google Scholar] [CrossRef] [PubMed]
- Oishi, N.; Segawa, T.; Miyake, K.; Mochizuki, K.; Kondo, T. Incidence, clinicopathological features and genetics of in-situ follicular neoplasia: A comprehensive screening study in a Japanese cohort. Histopathology 2022, 80, 820–826. [Google Scholar] [CrossRef]
- Pillai, R.K.; Surti, U.; Swerdlow, S.H. Follicular lymphoma-like B cells of uncertain significance (in situ follicular lymphoma) may infrequently progress, but precedes follicular lymphoma, is associated with other overt lymphomas and mimics follicular lymphoma in flow cytometric studies. Haematologica 2013, 98, 1571–1580. [Google Scholar] [CrossRef] [PubMed]
- Cong, P.; Raffeld, M.; Teruya-Feldstein, J.; Sorbara, L.; Pittaluga, S.; Jaffe, E.S. In situ localization of follicular lymphoma: Description and analysis by laser capture microdissection. Blood 2002, 99, 3376–3382. [Google Scholar] [CrossRef] [PubMed]
- Cheung, M.C.; Bailey, D.; Pennell, N.; Imrie, K.R.; Berinstein, N.L.; Amato, D.; Ghorab, Z. In situ localization of follicular lymphoma: Evidence for subclinical systemic disease with detection of an identical BCL-2/IGH fusion gene in blood and lymph node. Leukemia 2009, 23, 1176–1179. [Google Scholar] [CrossRef] [PubMed]
- Sungalee, S.; Mamessier, E.; Morgado, E.; Grégoire, E.; Brohawn, P.Z.; Morehouse, C.A.; Jouve, N.; Monvoisin, C.; Menard, C.; Debroas, G.; et al. Germinal center reentries of BCL2-overexpressing B cells drive follicular lymphoma progression. J. Clin. Invest. 2014, 124, 5337–5351. [Google Scholar] [CrossRef]
- Jegalian, A.G.; Eberle, F.C.; Pack, S.D.; Mirvis, M.; Raffeld, M.; Pittaluga, S.; Jaffe, E.S. Follicular lymphoma in situ: Clinical implications and comparisons with partial involvement by follicular lymphoma. Blood 2011, 118, 2976–2984. [Google Scholar] [CrossRef]
- Schmidt, J.; Salaverria, I.; Haake, A.; Bonzheim, I.; Adam, P.; Montes-Moreno, S.; Piris, M.A.; Fend, F.; Siebert, R.; Quintanilla-Martinez, L. Increasing genomic and epigenomic complexity in the clonal evolution from in situ to manifest t(14;18)-positive follicular lymphoma. Leukemia 2014, 28, 1103–1112. [Google Scholar] [CrossRef]
- Mamessier, E.; Song, J.Y.; Eberle, F.C.; Pack, S.; Drevet, C.; Chetaille, B.; Abdullaev, Z.; Adelaïde, J.; Birnbaum, D.; Chaffanet, M.; et al. Early lesions of follicular lymphoma: A genetic perspective. Haematologica 2014, 99, 481–488. [Google Scholar] [CrossRef]
- Mamessier, E.; Drevet, C.; Broussais-Guillaumot, F.; Mollichella, M.-L.; Garciaz, S.; Roulland, S.; Benchetrit, M.; Nadel, B.; Xerri, L. Contiguous follicular lymphoma and follicular lymphoma in situ harboring N-glycosylated sites. Haematologica 2015, 100, e155–e157. [Google Scholar] [CrossRef] [PubMed]
- Kosmidis, P.; Bonzheim, I.; Dufke, C.; Colak, S.; Hentrich, T.; Schroeder, C.; Bauer, P.; Adam, P.; Fend, F. Next generation sequencing of the clonal IGH rearrangement detects ongoing mutations and interfollicular trafficking in in situ follicular neoplasia. PLoS ONE 2017, 12, e0178503. [Google Scholar] [CrossRef]
- Schmidt, J.; Ramis-Zaldivar, J.E.; Bonzheim, I.; Steinhilber, J.; Müller, I.; Haake, A.; Yu, S.C.; Raffeld, M.; Fend, F.; Salaverria, I.; et al. CREBBP gene mutations are frequently detected in in situ follicular neoplasia. Blood 2018, 132, 2687–2690. [Google Scholar] [CrossRef] [PubMed]
- Bonzheim, I.; Salaverria, I.; Haake, A.; Gastl, G.; Adam, P.; Siebert, R.; Fend, F.; Quintanilla-Martinez, L. A unique case of follicular lymphoma provides insights to the clonal evolution from follicular lymphoma in situ to manifest follicular lymphoma. Blood 2011, 118, 3442–3444. [Google Scholar] [CrossRef] [PubMed]
- Vogelsberg, A.; Steinhilber, J.; Mankel, B.; Federmann, B.; Schmidt, J.; Montes-Mojarro, I.A.; Hüttl, K.; Rodriguez-Pinilla, M.; Baskaran, P.; Nahnsen, S.; et al. Genetic evolution of in situ follicular neoplasia to aggressive B-cell lymphoma of germinal center subtype. Haematologica 2021, 106, 2673–2681. [Google Scholar] [CrossRef]
- Dobson, R.; Wotherspoon, A.; Liu, S.A.; Cucco, F.; Chen, Z.; Tang, Y.; Du, M.-Q. Widespread in situ follicular neoplasia in patients who subsequently developed follicular lymphoma. J. Pathol. 2022, 256, 369–377. [Google Scholar] [CrossRef]
- Nathwani, B.N.; Metter, G.E.; Miller, T.P.; Burke, J.S.; Mann, R.B.; Barcos, M.; Kjeldsberg, C.R.; Dixon, D.O.; Winberg, C.D.; Whitcomb, C.C. What should be the morphologic criteria for the subdivision of follicular lymphomas? Blood 1986, 68, 837–845. [Google Scholar] [CrossRef]
- Menter, T.; Gasser, A.; Juskevicius, D.; Dirnhofer, S.; Tzankov, A. Diagnostic Utility of the Germinal Center-associated Markers GCET1, HGAL, and LMO2 in Hematolymphoid Neoplasms. Appl. Immunohistochem. Mol. Morphol. 2015, 23, 491–498. [Google Scholar] [CrossRef]
- Moore, E.M.; Swerdlow, S.H.; Gibson, S.E. Comparison of Myocyte Enhancer Factor 2B Versus Other Germinal Center-associated Antigens in the Differential Diagnosis of B-Cell Non-Hodgkin Lymphomas. Am. J. Surg. Pathol. 2018, 42, 342–350. [Google Scholar] [CrossRef]
- Adam, P.; Baumann, R.; Schmidt, J.; Bettio, S.; Weisel, K.; Bonzheim, I.; Fend, F.; Quintanilla-Martínez, L. The BCL2 E17 and SP66 antibodies discriminate 2 immunophenotypically and genetically distinct subgroups of conventionally BCL2-"negative" grade 1/2 follicular lymphomas. Hum. Pathol. 2013, 44, 1817–1826. [Google Scholar] [CrossRef]
- Klapper, W.; Hoster, E.; Rölver, L.; Schrader, C.; Janssen, D.; Tiemann, M.; Bernd, H.-W.; Determann, O.; Hansmann, M.-L.; Möller, P.; et al. Tumor sclerosis but not cell proliferation or malignancy grade is a prognostic marker in advanced-stage follicular lymphoma: The German Low Grade Lymphoma Study Group. J. Clin. Oncol. 2007, 25, 3330–3336. [Google Scholar] [CrossRef] [PubMed]
- Chiu, B.C.-H.; Dave, B.J.; Blair, A.; Gapstur, S.M.; Zahm, S.H.; Weisenburger, D.D. Agricultural pesticide use and risk of t(14;18)-defined subtypes of non-Hodgkin lymphoma. Blood 2006, 108, 1363–1369. [Google Scholar] [CrossRef]
- Dölken, G.; Dölken, L.; Hirt, C.; Fusch, C.; Rabkin, C.S.; Schüler, F. Age-dependent prevalence and frequency of circulating t(14;18)-positive cells in the peripheral blood of healthy individuals. J. Natl. Cancer Inst. Monogr. 2008, 2008, 44–47. [Google Scholar] [CrossRef]
- Roulland, S.; Navarro, J.-M.; Grenot, P.; Milili, M.; Agopian, J.; Montpellier, B.; Gauduchon, P.; Lebailly, P.; Schiff, C.; Nadel, B. Follicular lymphoma-like B cells in healthy individuals: A novel intermediate step in early lymphomagenesis. J. Exp. Med. 2006, 203, 2425–2431. [Google Scholar] [CrossRef]
- Green, M.R.; Gentles, A.J.; Nair, R.V.; Irish, J.M.; Kihira, S.; Liu, C.L.; Kela, I.; Hopmans, E.S.; Myklebust, J.H.; Ji, H.; et al. Hierarchy in somatic mutations arising during genomic evolution and progression of follicular lymphoma. Blood 2013, 121, 1604–1611. [Google Scholar] [CrossRef] [PubMed]
- Okosun, J.; Bödör, C.; Wang, J.; Araf, S.; Yang, C.-Y.; Pan, C.; Boller, S.; Cittaro, D.; Bozek, M.; Iqbal, S.; et al. Integrated genomic analysis identifies recurrent mutations and evolution patterns driving the initiation and progression of follicular lymphoma. Nat. Genet. 2014, 46, 176–181. [Google Scholar] [CrossRef] [PubMed]
- Pickard, L.; Palladino, G.; Okosun, J. Follicular lymphoma genomics. Leuk. Lymphoma 2020, 61, 2313–2323. [Google Scholar] [CrossRef]
- Huet, S.; Sujobert, P.; Salles, G. From genetics to the clinic: A translational perspective on follicular lymphoma. Nat. Rev. Cancer 2018, 18, 224–239. [Google Scholar] [CrossRef]
- Cheung, K.-J.J.; Johnson, N.A.; Affleck, J.G.; Severson, T.; Steidl, C.; Ben-Neriah, S.; Schein, J.; Morin, R.D.; Moore, R.; Shah, S.P.; et al. Acquired TNFRSF14 mutations in follicular lymphoma are associated with worse prognosis. Cancer Res. 2010, 70, 9166–9174. [Google Scholar] [CrossRef]
- Martin-Guerrero, I.; Salaverria, I.; Burkhardt, B.; Szczepanowski, M.; Baudis, M.; Bens, S.; de Leval, L.; Garcia-Orad, A.; Horn, H.; Lisfeld, J.; et al. Recurrent loss of heterozygosity in 1p36 associated with TNFRSF14 mutations in IRF4 translocation negative pediatric follicular lymphomas. Haematologica 2013, 98, 1237–1241. [Google Scholar] [CrossRef]
- Guo, Y.; Karube, K.; Kawano, R.; Suzumiya, J.; Takeshita, M.; Kikuchi, M.; Huang, G.-S.; Li, Q.; Ohshima, K. Bcl2-negative follicular lymphomas frequently have Bcl6 translocation and/or Bcl6 or p53 expression. Pathol. Int. 2007, 57, 148–152. [Google Scholar] [CrossRef]
- Horsman, D.E.; Okamoto, I.; Ludkovski, O.; Le, N.; Harder, L.; Gesk, S.; Siebert, R.; Chhanabhai, M.; Sehn, L.; Connors, J.M.; et al. Follicular lymphoma lacking the t(14;18)(q32;q21): Identification of two disease subtypes. Br. J. Haematol. 2003, 120, 424–433. [Google Scholar] [CrossRef] [PubMed]
- Leich, E.; Hoster, E.; Wartenberg, M.; Unterhalt, M.; Siebert, R.; Koch, K.; Klapper, W.; Engelhard, M.; Puppe, B.; Horn, H.; et al. Similar clinical features in follicular lymphomas with and without breaks in the BCL2 locus. Leukemia 2016, 30, 854–860. [Google Scholar] [CrossRef] [PubMed]
- Kridel, R.; Mottok, A.; Farinha, P.; Ben-Neriah, S.; Ennishi, D.; Zheng, Y.; Chavez, E.A.; Shulha, H.P.; Tan, K.; Chan, F.C.; et al. Cell of origin of transformed follicular lymphoma. Blood 2015, 126, 2118–2127. [Google Scholar] [CrossRef] [PubMed]
- Leich, E.; Salaverria, I.; Bea, S.; Zettl, A.; Wright, G.; Moreno, V.; Gascoyne, R.D.; Chan, W.-C.; Braziel, R.M.; Rimsza, L.M.; et al. Follicular lymphomas with and without translocation t(14;18) differ in gene expression profiles and genetic alterations. Blood 2009, 114, 826–834. [Google Scholar] [CrossRef]
- Leich, E.; Zamo, A.; Horn, H.; Haralambieva, E.; Puppe, B.; Gascoyne, R.D.; Chan, W.-C.; Braziel, R.M.; Rimsza, L.M.; Weisenburger, D.D.; et al. MicroRNA profiles of t(14;18)-negative follicular lymphoma support a late germinal center B-cell phenotype. Blood 2011, 118, 5550–5558. [Google Scholar] [CrossRef]
- Zamò, A.; Pischimarov, J.; Schlesner, M.; Rosenstiel, P.; Bomben, R.; Horn, H.; Grieb, T.; Nedeva, T.; López, C.; Haake, A.; et al. Differences between BCL2-break positive and negative follicular lymphoma unraveled by whole-exome sequencing. Leukemia 2018, 32, 685–693. [Google Scholar] [CrossRef]
- Nann, D.; Ramis-Zaldivar, J.E.; Müller, I.; Gonzalez-Farre, B.; Schmidt, J.; Egan, C.; Salmeron-Villalobos, J.; Clot, G.; Mattern, S.; Otto, F.; et al. Follicular lymphoma t(14;18)-negative is genetically a heterogeneous disease. Blood Adv. 2020, 4, 5652–5665. [Google Scholar] [CrossRef]
- Ortega-Molina, A.; Boss, I.W.; Canela, A.; Pan, H.; Jiang, Y.; Zhao, C.; Jiang, M.; Hu, D.; Agirre, X.; Niesvizky, I.; et al. The histone lysine methyltransferase KMT2D sustains a gene expression program that represses B cell lymphoma development. Nat. Med. 2015, 21, 1199–1208. [Google Scholar] [CrossRef]
- Leich, E.; Maier, C.; Bomben, R.; Vit, F.; Bosi, A.; Horn, H.; Gattei, V.; Ott, G.; Rosenwald, A.; Zamò, A. Follicular lymphoma subgroups with and without t(14;18) differ in their N-glycosylation pattern and IGHV usage. Blood Adv. 2021, 5, 4890–4900. [Google Scholar] [CrossRef]
- Horn, H.; Jurinovic, V.; Leich, E.; Kalmbach, S.; Bausinger, J.; Staiger, A.M.; Kurz, K.S.; Möller, P.; Bernd, H.-W.; Feller, A.C.; et al. Molecular Cytogenetic Profiling Reveals Similarities and Differences Between Localized Nodal and Systemic Follicular Lymphomas. Hemasphere 2022, 6, e767. [Google Scholar] [CrossRef] [PubMed]
- Staiger, A.M.; Hoster, E.; Jurinovic, V.; Winter, S.; Leich, E.; Kalla, C.; Möller, P.; Bernd, H.-W.; Feller, A.C.; Koch, K.; et al. Localized- and advanced-stage follicular lymphomas differ in their gene expression profiles. Blood 2020, 135, 181–190. [Google Scholar] [CrossRef] [PubMed]
- Los-de Vries, G.T.; Stevens, W.B.C.; van Dijk, E.; Langois-Jacques, C.; Clear, A.J.; Stathi, P.; Roemer, M.G.M.; Mendeville, M.; Hijmering, N.J.; Sander, B.; et al. Genomic and microenvironmental landscape of stage I follicular lymphoma, compared with stage III/IV. Blood Adv. 2022, 6, 5482–5493. [Google Scholar] [CrossRef]
- Dave, S.S.; Wright, G.; Tan, B.; Rosenwald, A.; Gascoyne, R.D.; Chan, W.C.; Fisher, R.I.; Braziel, R.M.; Rimsza, L.M.; Grogan, T.M.; et al. Prediction of survival in follicular lymphoma based on molecular features of tumor-infiltrating immune cells. N. Engl. J. Med. 2004, 351, 2159–2169. [Google Scholar] [CrossRef] [PubMed]
- Kumar, E.; Pickard, L.; Okosun, J. Pathogenesis of follicular lymphoma: Genetics to the microenvironment to clinical translation. Br. J. Haematol. 2021, 194, 810–821. [Google Scholar] [CrossRef]
- Koch, K.; Hoster, E.; Unterhalt, M.; Ott, G.; Rosenwald, A.; Hansmann, M.L.; Engelhard, M.; Hiddemann, W.; Klapper, W. The composition of the microenvironment in follicular lymphoma is associated with the stage of the disease. Hum. Pathol. 2012, 43, 2274–2281. [Google Scholar] [CrossRef]
- Ménard, C.; Rossille, D.; Dulong, J.; Nguyen, T.-T.; Papa, I.; Latour, M.; Bescher, N.; Bezier, I.; Chouteau, M.; Fest, T.; et al. Lenalidomide triggers T-cell effector functions in vivo in patients with follicular lymphoma. Blood Adv. 2021, 5, 2063–2074. [Google Scholar] [CrossRef]
- Lamaison, C.; Latour, S.; Hélaine, N.; Le Morvan, V.; Saint-Vanne, J.; Mahouche, I.; Monvoisin, C.; Dussert, C.; Andrique, L.; Deleurme, L.; et al. A novel 3D culture model recapitulates primary FL B-cell features and promotes their survival. Blood Adv. 2021, 5, 5372–5386. [Google Scholar] [CrossRef]
- El Behery, R.; Laurini, J.A.; Weisenburger, D.D.; Smith, L.M.; Dave, B.J.; Yuan, J.; Fu, K.; Chan, W.C.; Nathwani, B.N.; Bierman, P.J.; et al. Follicular large cleaved cell (centrocytic) lymphoma: An unrecognized variant of follicular lymphoma. Hum. Pathol. 2018, 72, 180–190. [Google Scholar] [CrossRef]
- Laurent, C.; Adélaïde, J.; Guille, A.; Tesson, B.; Gat, E.; Evrard, S.; Escudié, F.; Syrykh, C.; Canioni, D.; Fabiani, B.; et al. High-grade Follicular Lymphomas Exhibit Clinicopathologic, Cytogenetic, and Molecular Diversity Extending Beyond Grades 3A and 3B. Am. J. Surg. Pathol. 2021, 45, 1324–1336. [Google Scholar] [CrossRef] [PubMed]
- Horn, H.; Schmelter, C.; Leich, E.; Salaverria, I.; Katzenberger, T.; Ott, M.M.; Kalla, J.; Romero, M.; Siebert, R.; Rosenwald, A.; et al. Follicular lymphoma grade 3B is a distinct neoplasm according to cytogenetic and immunohistochemical profiles. Haematologica 2011, 96, 1327–1334. [Google Scholar] [CrossRef] [PubMed]
- Katzenberger, T.; Kalla, J.; Leich, E.; Stöcklein, H.; Hartmann, E.; Barnickel, S.; Wessendorf, S.; Ott, M.M.; Müller-Hermelink, H.K.; Rosenwald, A.; et al. A distinctive subtype of t(14;18)-negative nodal follicular non-Hodgkin lymphoma characterized by a predominantly diffuse growth pattern and deletions in the chromosomal region 1p36. Blood 2009, 113, 1053–1061. [Google Scholar] [CrossRef] [PubMed]
- Siddiqi, I.N.; Friedman, J.; Barry-Holson, K.Q.; Ma, C.; Thodima, V.; Kang, I.; Padmanabhan, R.; Dias, L.M.; Kelly, K.R.; Brynes, R.K.; et al. Characterization of a variant of t(14;18) negative nodal diffuse follicular lymphoma with CD23 expression, 1p36/TNFRSF14 abnormalities, and STAT6 mutations. Mod. Pathol. 2016, 29, 570–581. [Google Scholar] [CrossRef] [PubMed]
- Zamò, A.; Pischimarov, J.; Horn, H.; Ott, G.; Rosenwald, A.; Leich, E. The exomic landscape of t(14;18)-negative diffuse follicular lymphoma with 1p36 deletion. Br. J. Haematol. 2018, 180, 391–394. [Google Scholar] [CrossRef]
- Xian, R.R.; Xie, Y.; Haley, L.M.; Yonescu, R.; Pallavajjala, A.; Pittaluga, S.; Jaffe, E.S.; Duffield, A.S.; McCall, C.M.; Gheith, S.M.F.; et al. CREBBP and STAT6 co-mutation and 16p13 and 1p36 loss define the t(14;18)-negative diffuse variant of follicular lymphoma. Blood Cancer J. 2020, 10, 69. [Google Scholar] [CrossRef]
- Morin, R.D.; Assouline, S.; Alcaide, M.; Mohajeri, A.; Johnston, R.L.; Chong, L.; Grewal, J.; Yu, S.; Fornika, D.; Bushell, K.; et al. Genetic Landscapes of Relapsed and Refractory Diffuse Large B-Cell Lymphomas. Clin. Cancer Res. 2016, 22, 2290–2300. [Google Scholar] [CrossRef] [PubMed]
- Wurster, A.L.; Rodgers, V.L.; White, M.F.; Rothstein, T.L.; Grusby, M.J. Interleukin-4-mediated protection of primary B cells from apoptosis through Stat6-dependent up-regulation of Bcl-xL. J. Biol. Chem. 2002, 277, 27169–27175. [Google Scholar] [CrossRef]
- Ott, G.; Katzenberger, T.; Lohr, A.; Kindelberger, S.; Rüdiger, T.; Wilhelm, M.; Kalla, J.; Rosenwald, A.; Müller, J.G.; Ott, M.M.; et al. Cytomorphologic, immunohistochemical, and cytogenetic profiles of follicular lymphoma: 2 types of follicular lymphoma grade 3. Blood 2002, 99, 3806–3812. [Google Scholar] [CrossRef]
- Katzenberger, T.; Ott, G.; Klein, T.; Kalla, J.; Müller-Hermelink, H.K.; Ott, M.M. Cytogenetic alterations affecting BCL6 are predominantly found in follicular lymphomas grade 3B with a diffuse large B-cell component. Am. J. Pathol. 2004, 165, 481–490. [Google Scholar] [CrossRef]
- Koch, K.; Hoster, E.; Ziepert, M.; Unterhalt, M.; Ott, G.; Rosenwald, A.; Hansmann, M.L.; Bernd, W.; Stein, H.; Pöschel, V.; et al. Clinical, pathological and genetic features of follicular lymphoma grade 3A: A joint analysis of the German low-grade and high-grade lymphoma study groups GLSG and DSHNHL. Ann. Oncol. 2016, 27, 1323–1329. [Google Scholar] [CrossRef]
- Horn, H.; Kohler, C.; Witzig, R.; Kreuz, M.; Leich, E.; Klapper, W.; Hummel, M.; Loeffler, M.; Trümper, L.; Spang, R.; et al. Gene expression profiling reveals a close relationship between follicular lymphoma grade 3A and 3B, but distinct profiles of follicular lymphoma grade 1 and 2. Haematologica 2018, 103, 1182–1190. [Google Scholar] [CrossRef] [PubMed]
- Louissaint, A.; Ackerman, A.M.; Dias-Santagata, D.; Ferry, J.A.; Hochberg, E.P.; Huang, M.S.; Iafrate, A.J.; Lara, D.O.; Pinkus, G.S.; Salaverria, I.; et al. Pediatric-type nodal follicular lymphoma: An indolent clonal proliferation in children and adults with high proliferation index and no BCL2 rearrangement. Blood 2012, 120, 2395–2404. [Google Scholar] [CrossRef]
- Louissaint, A.; Schafernak, K.T.; Geyer, J.T.; Kovach, A.E.; Ghandi, M.; Gratzinger, D.; Roth, C.G.; Paxton, C.N.; Kim, S.; Namgyal, C.; et al. Pediatric-type nodal follicular lymphoma: A biologically distinct lymphoma with frequent MAPK pathway mutations. Blood 2016, 128, 1093–1100. [Google Scholar] [CrossRef]
- Oschlies, I.; Salaverria, I.; Mahn, F.; Meinhardt, A.; Zimmermann, M.; Woessmann, W.; Burkhardt, B.; Gesk, S.; Krams, M.; Reiter, A.; et al. Pediatric follicular lymphoma—A clinico-pathological study of a population-based series of patients treated within the Non-Hodgkin’s Lymphoma—Berlin-Frankfurt-Munster (NHL-BFM) multicenter trials. Haematologica 2010, 95, 253–259. [Google Scholar] [CrossRef] [PubMed]
- Agrawal, R.; Wang, J. Pediatric follicular lymphoma: A rare clinicopathologic entity. Arch. Pathol. Lab. Med. 2009, 133, 142–146. [Google Scholar] [CrossRef]
- Schmidt, J.; Gong, S.; Marafioti, T.; Mankel, B.; Gonzalez-Farre, B.; Balagué, O.; Mozos, A.; Cabeçadas, J.; van der Walt, J.; Hoehn, D.; et al. Genome-wide analysis of pediatric-type follicular lymphoma reveals low genetic complexity and recurrent alterations of TNFRSF14 gene. Blood 2016, 128, 1101–1111. [Google Scholar] [CrossRef]
- Agostinelli, C.; Akarca, A.U.; Ramsay, A.; Rizvi, H.; Rodriguez-Justo, M.; Pomplun, S.; Proctor, I.; Sabattini, E.; Linch, D.; Daw, S.; et al. Novel markers in pediatric-type follicular lymphoma. Virchows Arch. 2019, 475, 771–779. [Google Scholar] [CrossRef]
- Schmidt, J.; Ramis-Zaldivar, J.E.; Nadeu, F.; Gonzalez-Farre, B.; Navarro, A.; Egan, C.; Montes-Mojarro, I.A.; Marafioti, T.; Cabeçadas, J.; van der Walt, J.; et al. Mutations of MAP2K1 are frequent in pediatric-type follicular lymphoma and result in ERK pathway activation. Blood 2017, 130, 323–327. [Google Scholar] [CrossRef] [PubMed]
- Takata, K.; Okada, H.; Ohmiya, N.; Nakamura, S.; Kitadai, Y.; Tari, A.; Akamatsu, T.; Kawai, H.; Tanaka, S.; Araki, H.; et al. Primary gastrointestinal follicular lymphoma involving the duodenal second portion is a distinct entity: A multicenter, retrospective analysis in Japan. Cancer Sci. 2011, 102, 1532–1536. [Google Scholar] [CrossRef]
- Schmatz, A.-I.; Streubel, B.; Kretschmer-Chott, E.; Püspök, A.; Jäger, U.; Mannhalter, C.; Tiemann, M.; Ott, G.; Fischbach, W.; Herzog, P.; et al. Primary follicular lymphoma of the duodenum is a distinct mucosal/submucosal variant of follicular lymphoma: A retrospective study of 63 cases. J. Clin. Oncol. 2011, 29, 1445–1451. [Google Scholar] [CrossRef]
- Hellmuth, J.C.; Louissaint, A.; Szczepanowski, M.; Haebe, S.; Pastore, A.; Alig, S.; Staiger, A.M.; Hartmann, S.; Kridel, R.; Ducar, M.D.; et al. Duodenal-type and nodal follicular lymphomas differ by their immune microenvironment rather than their mutation profiles. Blood 2018, 132, 1695–1702. [Google Scholar] [CrossRef] [PubMed]
- Tsuyama, N.; Yokoyama, M.; Fujisaki, J.; Oguchi, M.; Terui, Y.; Takeuchi, K. Villous colonization (glove balloon sign): A histopathological diagnostic marker for follicular lymphomas with duodenal involvement including duodenal-type follicular lymphoma. Pathol. Int. 2019, 69, 48–50. [Google Scholar] [CrossRef] [PubMed]
- Drillenburg, P.; van der Voort, R.; Koopman, G.; Dragosics, B.; van Krieken, J.H.; Kluin, P.; Meenan, J.; Lazarovits, A.I.; Radaszkiewicz, T.; Pals, S.T. Preferential expression of the mucosal homing receptor integrin alpha 4 beta 7 in gastrointestinal non-Hodgkin’s lymphomas. Am. J. Pathol. 1997, 150, 919–927. [Google Scholar] [PubMed]
- Takata, K.; Sato, Y.; Nakamura, N.; Tokunaka, M.; Miki, Y.; Yukie Kikuti, Y.; Igarashi, K.; Ito, E.; Harigae, H.; Kato, S.; et al. Duodenal follicular lymphoma lacks AID but expresses BACH2 and has memory B-cell characteristics. Mod. Pathol. 2013, 26, 22–31. [Google Scholar] [CrossRef] [PubMed]
- Takata, K.; Tanino, M.; Ennishi, D.; Tari, A.; Sato, Y.; Okada, H.; Maeda, Y.; Goto, N.; Araki, H.; Harada, M.; et al. Duodenal follicular lymphoma: Comprehensive gene expression analysis with insights into pathogenesis. Cancer Sci. 2014, 105, 608–615. [Google Scholar] [CrossRef]
- Sato, Y.; Ichimura, K.; Tanaka, T.; Takata, K.; Morito, T.; Sato, H.; Kondo, E.; Yanai, H.; Ohara, N.; Oka, T.; et al. Duodenal follicular lymphomas share common characteristics with mucosa-associated lymphoid tissue lymphomas. J. Clin. Pathol. 2008, 61, 377–381. [Google Scholar] [CrossRef]
- Zinzani, P.L.; Quaglino, P.; Pimpinelli, N.; Berti, E.; Baliva, G.; Rupoli, S.; Martelli, M.; Alaibac, M.; Borroni, G.; Chimenti, S.; et al. Prognostic factors in primary cutaneous B-cell lymphoma: The Italian Study Group for Cutaneous Lymphomas. J. Clin. Oncol. 2006, 24, 1376–1382. [Google Scholar] [CrossRef]
- Senff, N.J.; Hoefnagel, J.J.; Jansen, P.M.; Vermeer, M.H.; van Baarlen, J.; Blokx, W.A.; Canninga-van Dijk, M.R.; Geerts, M.-L.; Hebeda, K.M.; Kluin, P.M.; et al. Reclassification of 300 primary cutaneous B-Cell lymphomas according to the new WHO-EORTC classification for cutaneous lymphomas: Comparison with previous classifications and identification of prognostic markers. J. Clin. Oncol. 2007, 25, 1581–1587. [Google Scholar] [CrossRef]
- Vergier, B.; Belaud-Rotureau, M.-A.; Benassy, M.-N.; Beylot-Barry, M.; Dubus, P.; Delaunay, M.; Garroste, J.-C.; Taine, L.; Merlio, J.-P. Neoplastic cells do not carry bcl2-JH rearrangements detected in a subset of primary cutaneous follicle center B-cell lymphomas. Am. J. Surg. Pathol. 2004, 28, 748–755. [Google Scholar] [CrossRef]
- Abdul-Wahab, A.; Tang, S.-Y.; Robson, A.; Morris, S.; Agar, N.; Wain, E.M.; Child, F.; Scarisbrick, J.; Neat, M.; Whittaker, S. Chromosomal anomalies in primary cutaneous follicle center cell lymphoma do not portend a poor prognosis. J. Am. Acad. Dermatol. 2014, 70, 1010–1020. [Google Scholar] [CrossRef]
- Pham-Ledard, A.; Cowppli-Bony, A.; Doussau, A.; Prochazkova-Carlotti, M.; Laharanne, E.; Jouary, T.; Belaud-Rotureau, M.-A.; Vergier, B.; Merlio, J.-P.; Beylot-Barry, M. Diagnostic and prognostic value of BCL2 rearrangement in 53 patients with follicular lymphoma presenting as primary skin lesions. Am. J. Clin. Pathol. 2015, 143, 362–373. [Google Scholar] [CrossRef] [PubMed]
- Zhou, X.A.; Yang, J.; Ringbloom, K.G.; Martinez-Escala, M.E.; Stevenson, K.E.; Wenzel, A.T.; Fantini, D.; Martin, H.K.; Moy, A.P.; Morgan, E.A.; et al. Genomic landscape of cutaneous follicular lymphomas reveals 2 subgroups with clinically predictive molecular features. Blood Adv. 2021, 5, 649–661. [Google Scholar] [CrossRef]
- Fujiwara, M.; Morales, A.V.; Seo, K.; Kim, Y.H.; Arber, D.A.; Sundram, U.N. Clonal identity and differences in primary cutaneous B-cell lymphoma occurring at different sites or time points in the same patient. Am. J. Dermatopathol. 2013, 35, 11–18. [Google Scholar] [CrossRef]
- Gellrich, S.; Rutz, S.; Golembowski, S.; Jacobs, C.; von Zimmermann, M.; Lorenz, P.; Audring, H.; Muche, M.; Sterry, W.; Jahn, S. Primary cutaneous follicle center cell lymphomas and large B cell lymphomas of the leg descend from germinal center cells. A single cell polymerase chain reaction analysis. J. Invest. Dermatol. 2001, 117, 1512–1520. [Google Scholar] [CrossRef] [PubMed]
- Morales, A.V.; Arber, D.A.; Seo, K.; Kohler, S.; Kim, Y.H.; Sundram, U.N. Evaluation of B-cell clonality using the BIOMED-2 PCR method effectively distinguishes cutaneous B-cell lymphoma from benign lymphoid infiltrates. Am. J. Dermatopathol. 2008, 30, 425–430. [Google Scholar] [CrossRef] [PubMed]
- Barasch, N.J.K.; Liu, Y.-C.; Ho, J.; Bailey, N.; Aggarwal, N.; Cook, J.R.; Swerdlow, S.H. The molecular landscape and other distinctive features of primary cutaneous follicle center lymphoma. Hum. Pathol. 2020, 106, 93–105. [Google Scholar] [CrossRef]
- Koning, M.T.; Quinten, E.; Zoutman, W.H.; Kiełbasa, S.M.; Mei, H.; van Bergen, C.A.M.; Jansen, P.; Vergroesen, R.D.; Willemze, R.; Vermeer, M.H.; et al. Acquired N-Linked Glycosylation Motifs in B-Cell Receptors of Primary Cutaneous B-Cell Lymphoma and the Normal B-Cell Repertoire. J. Invest. Dermatol. 2019, 139, 2195–2203. [Google Scholar] [CrossRef]
- Caeser, R.; Gao, J.; Di Re, M.; Gong, C.; Hodson, D.J. Genetic manipulation and immortalized culture of ex vivo primary human germinal center B cells. Nat. Protoc. 2021, 16, 2499–2519. [Google Scholar] [CrossRef]

| Follicular Lymphoma (FL) |
| - Classic FL |
| - Predominantly diffuse FL |
| - FL with unusual cytological features |
| - Follicular large B-cell lymphoma |
| In situ follicular B-cell neoplasm |
| Paediatric-type follicular lymphoma |
| Duodenal-type follicular lymphoma |
| Primary cutaneous follicle center lymphoma |
Disclaimer/Publisher’s Note: The statements, opinions and data contained in all publications are solely those of the individual author(s) and contributor(s) and not of MDPI and/or the editor(s). MDPI and/or the editor(s) disclaim responsibility for any injury to people or property resulting from any ideas, methods, instructions or products referred to in the content. |
© 2023 by the authors. Licensee MDPI, Basel, Switzerland. This article is an open access article distributed under the terms and conditions of the Creative Commons Attribution (CC BY) license (https://creativecommons.org/licenses/by/4.0/).
Share and Cite
Kurz, K.S.; Kalmbach, S.; Ott, M.; Staiger, A.M.; Ott, G.; Horn, H. Follicular Lymphoma in the 5th Edition of the WHO-Classification of Haematolymphoid Neoplasms—Updated Classification and New Biological Data. Cancers 2023, 15, 785. https://doi.org/10.3390/cancers15030785
Kurz KS, Kalmbach S, Ott M, Staiger AM, Ott G, Horn H. Follicular Lymphoma in the 5th Edition of the WHO-Classification of Haematolymphoid Neoplasms—Updated Classification and New Biological Data. Cancers. 2023; 15(3):785. https://doi.org/10.3390/cancers15030785
Chicago/Turabian StyleKurz, Katrin S., Sabrina Kalmbach, Michaela Ott, Annette M. Staiger, German Ott, and Heike Horn. 2023. "Follicular Lymphoma in the 5th Edition of the WHO-Classification of Haematolymphoid Neoplasms—Updated Classification and New Biological Data" Cancers 15, no. 3: 785. https://doi.org/10.3390/cancers15030785
APA StyleKurz, K. S., Kalmbach, S., Ott, M., Staiger, A. M., Ott, G., & Horn, H. (2023). Follicular Lymphoma in the 5th Edition of the WHO-Classification of Haematolymphoid Neoplasms—Updated Classification and New Biological Data. Cancers, 15(3), 785. https://doi.org/10.3390/cancers15030785

